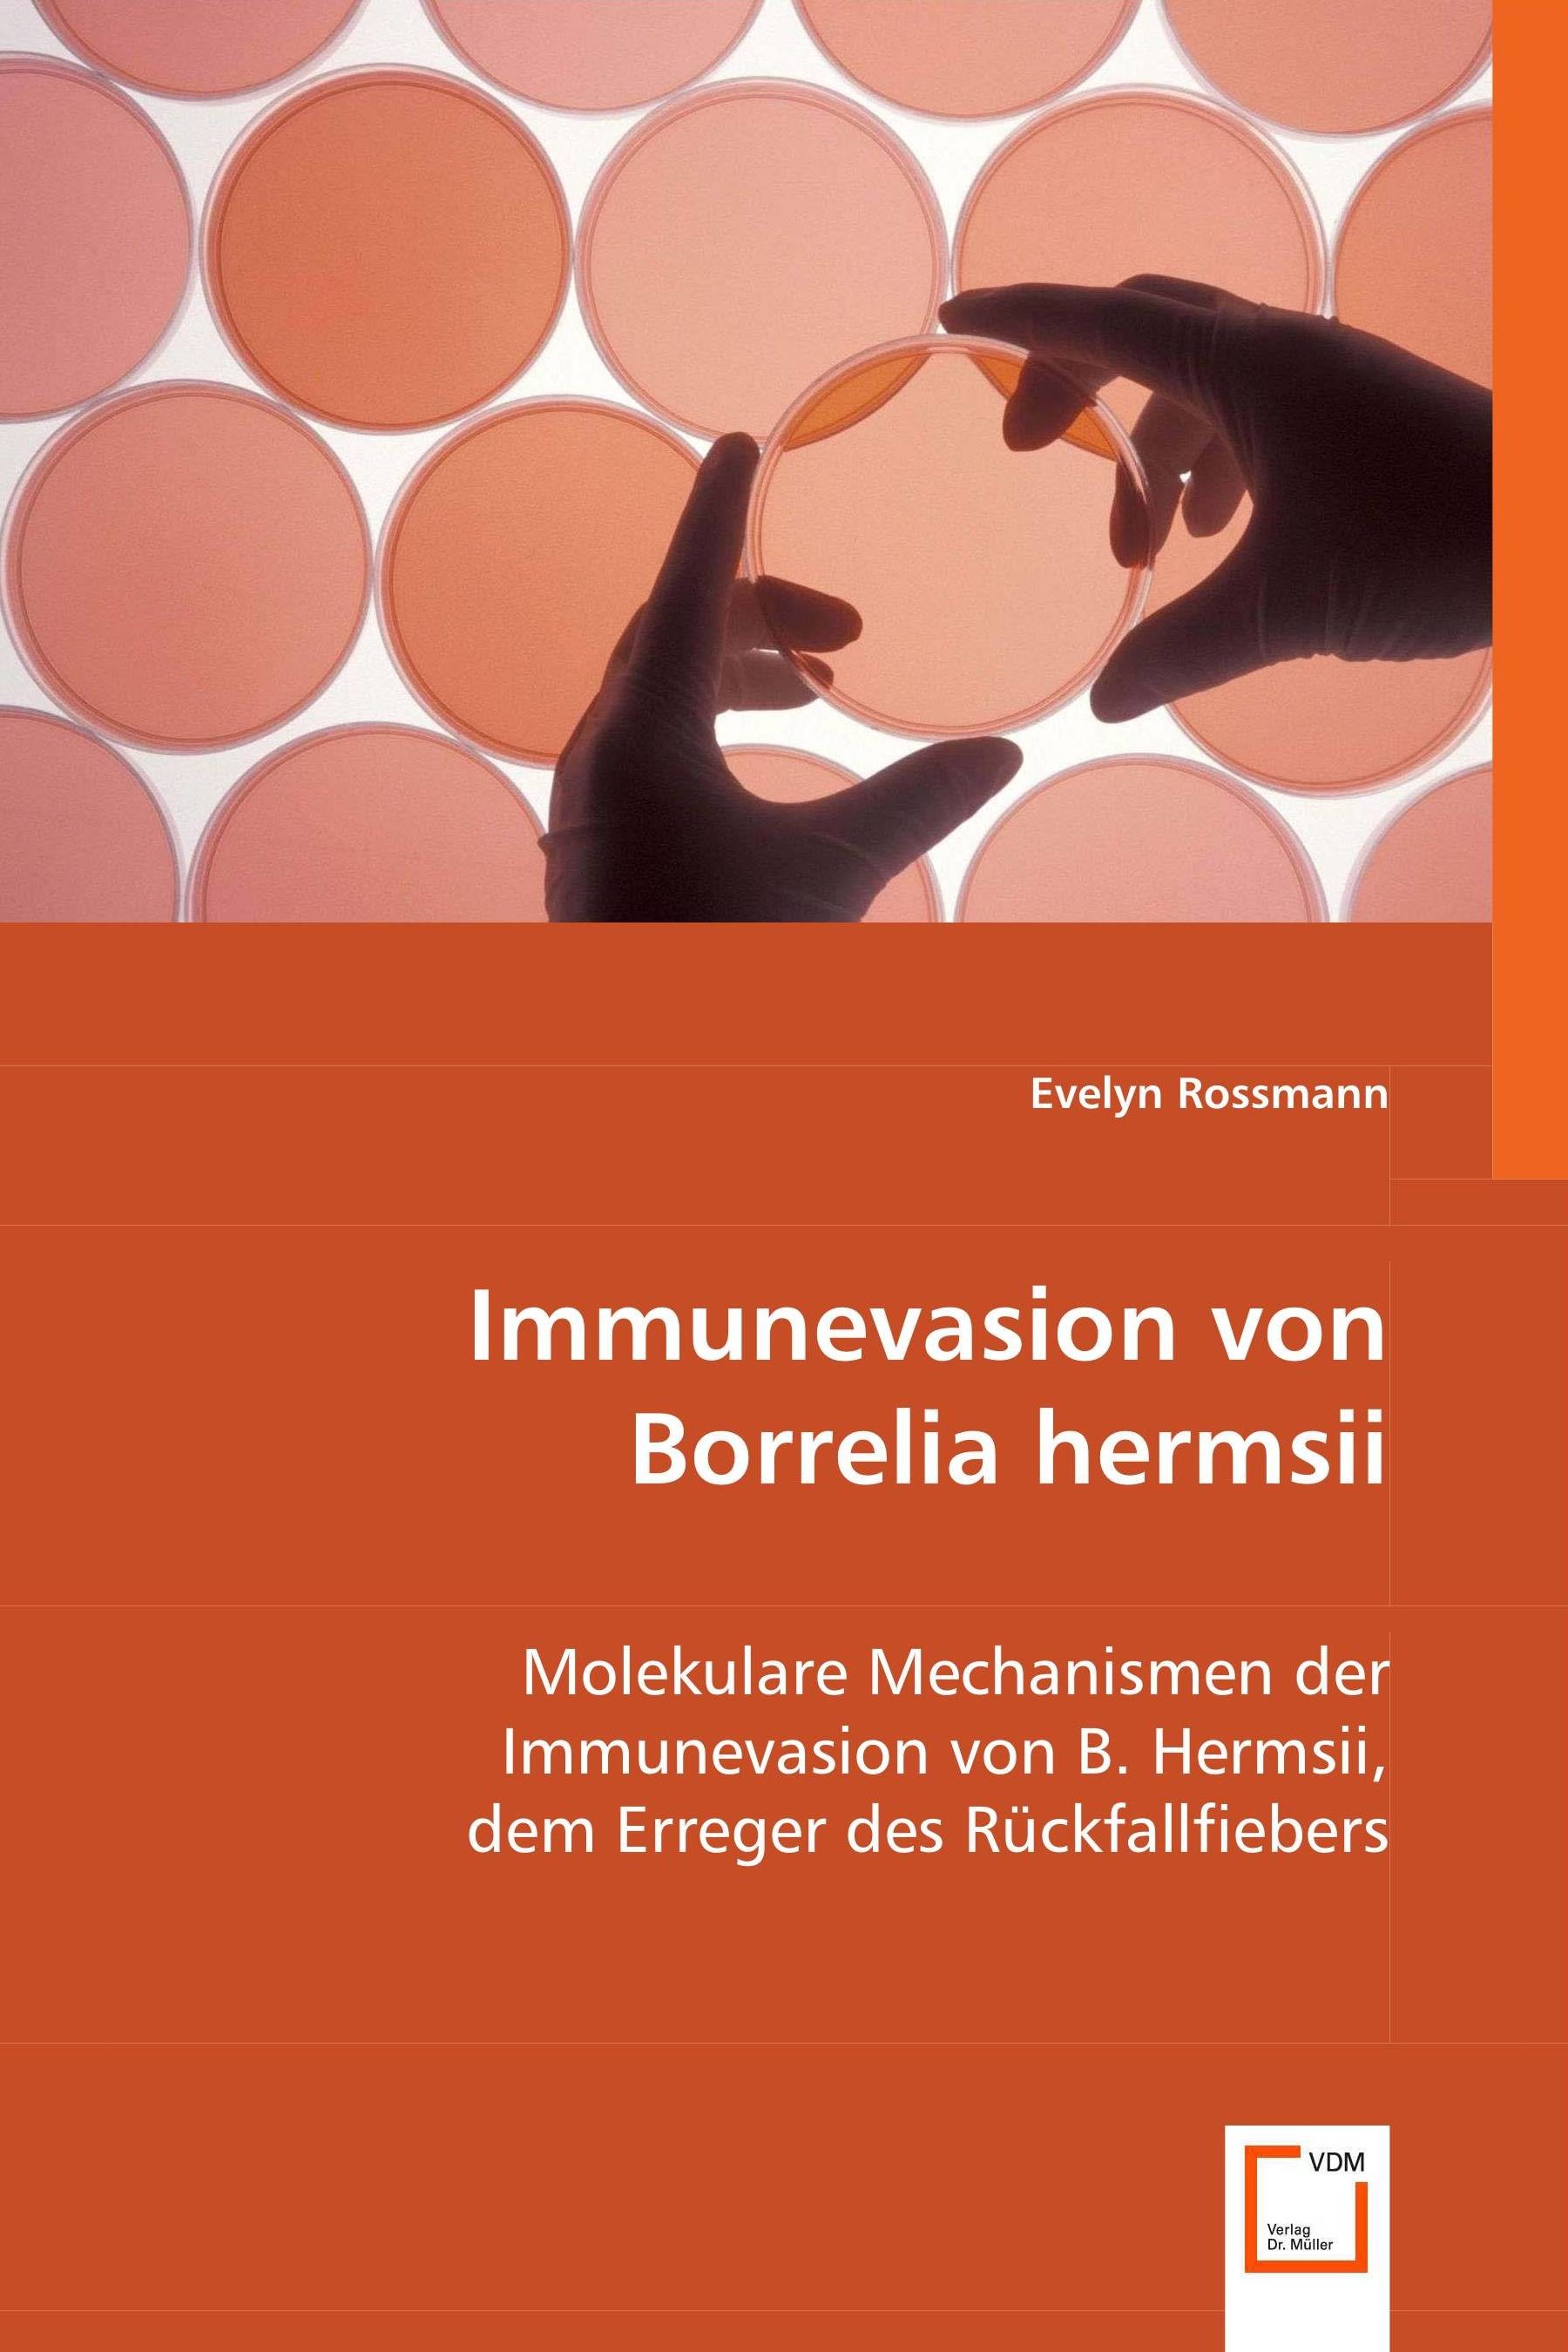
Immunevasion von Borrelia hermsii

Immunevasion von Borrelia hermsii
Molekulare Mechanismen der Immunevasion von B. hermsii, dem Erreger des Rückfallfiebers
| Auflage | 1. Auflage, 2008 |
| Verlag | VDM Verlag Dr. Mueller e.K. |
| ISBN | 9783639009606 |
Sofort zum Download (Download: PDF)
Produktbeschreibung
Rückfallfieber wird in Nordamerika primär durch die Spirochaete Borrelia hermsii verursacht. Ein einzigartiger Aspekt der Rückfallfieber-Spirochaeten ist ihre Fähigkeit, während der Infektion von Säugern hohe Zelldichten im Blut zu erreichen. Der pathogene Erreger nutzt vielfältige Strategien, um der angeborenen und erworbenen Immunantwort zu entkommen, im Blut zu persistieren und in Gewebe zu disseminieren. In dieser Arbeit wird ein Oberflächen-Protein von B. hermsii charakterisiert, welches in der Lage ist, Komplementregulatoren und Plasminogen, den Vorläufer der Serinprotease Plasmin, aus humanem Serum zu binden. Die Bindungsspezifität des Lipoproteins BhCRASP-1 (B. hermsii complement regulator acquiring surface protein 1) an Faktor H und Plasminogen ist möglicherweise ein Schlüsselmechanismus für das resistente Verhalten gegenüber der angeborenen Immunität sowie der Dissemination und Invasion von B. hermsii. Die Arbeit trägt zum Verständnis der molekularen Interaktionen von Rückfallfieber-Borrelien mit Wirtsfaktoren bei und zeigt Ansätze, deren Rolle in der Virulenz und Pathogenese von B. hermsii im Menschen zu verstehen.
geboren am 07.05.1975 in Mainz. Studium der Biologie an der Johannes Gutenberg Universität in Mainz. Diplomarbeit am Deutschen Krebsforschungszentrum (DKFZ)in Heidelberg bei Prof. Dirk Schadendorf. Promotion am Institut für Immunologie des Universitätsklinikums Heidelberg in der Arbeitsgruppe von Prof. Reiner Wallich.
geboren am 07.05.1975 in Mainz. Studium der Biologie an der Johannes Gutenberg Universität in Mainz. Diplomarbeit am Deutschen Krebsforschungszentrum (DKFZ)in Heidelberg bei Prof. Dirk Schadendorf. Promotion am Institut für Immunologie des Universitätsklinikums Heidelberg in der Arbeitsgruppe von Prof. Reiner Wallich.